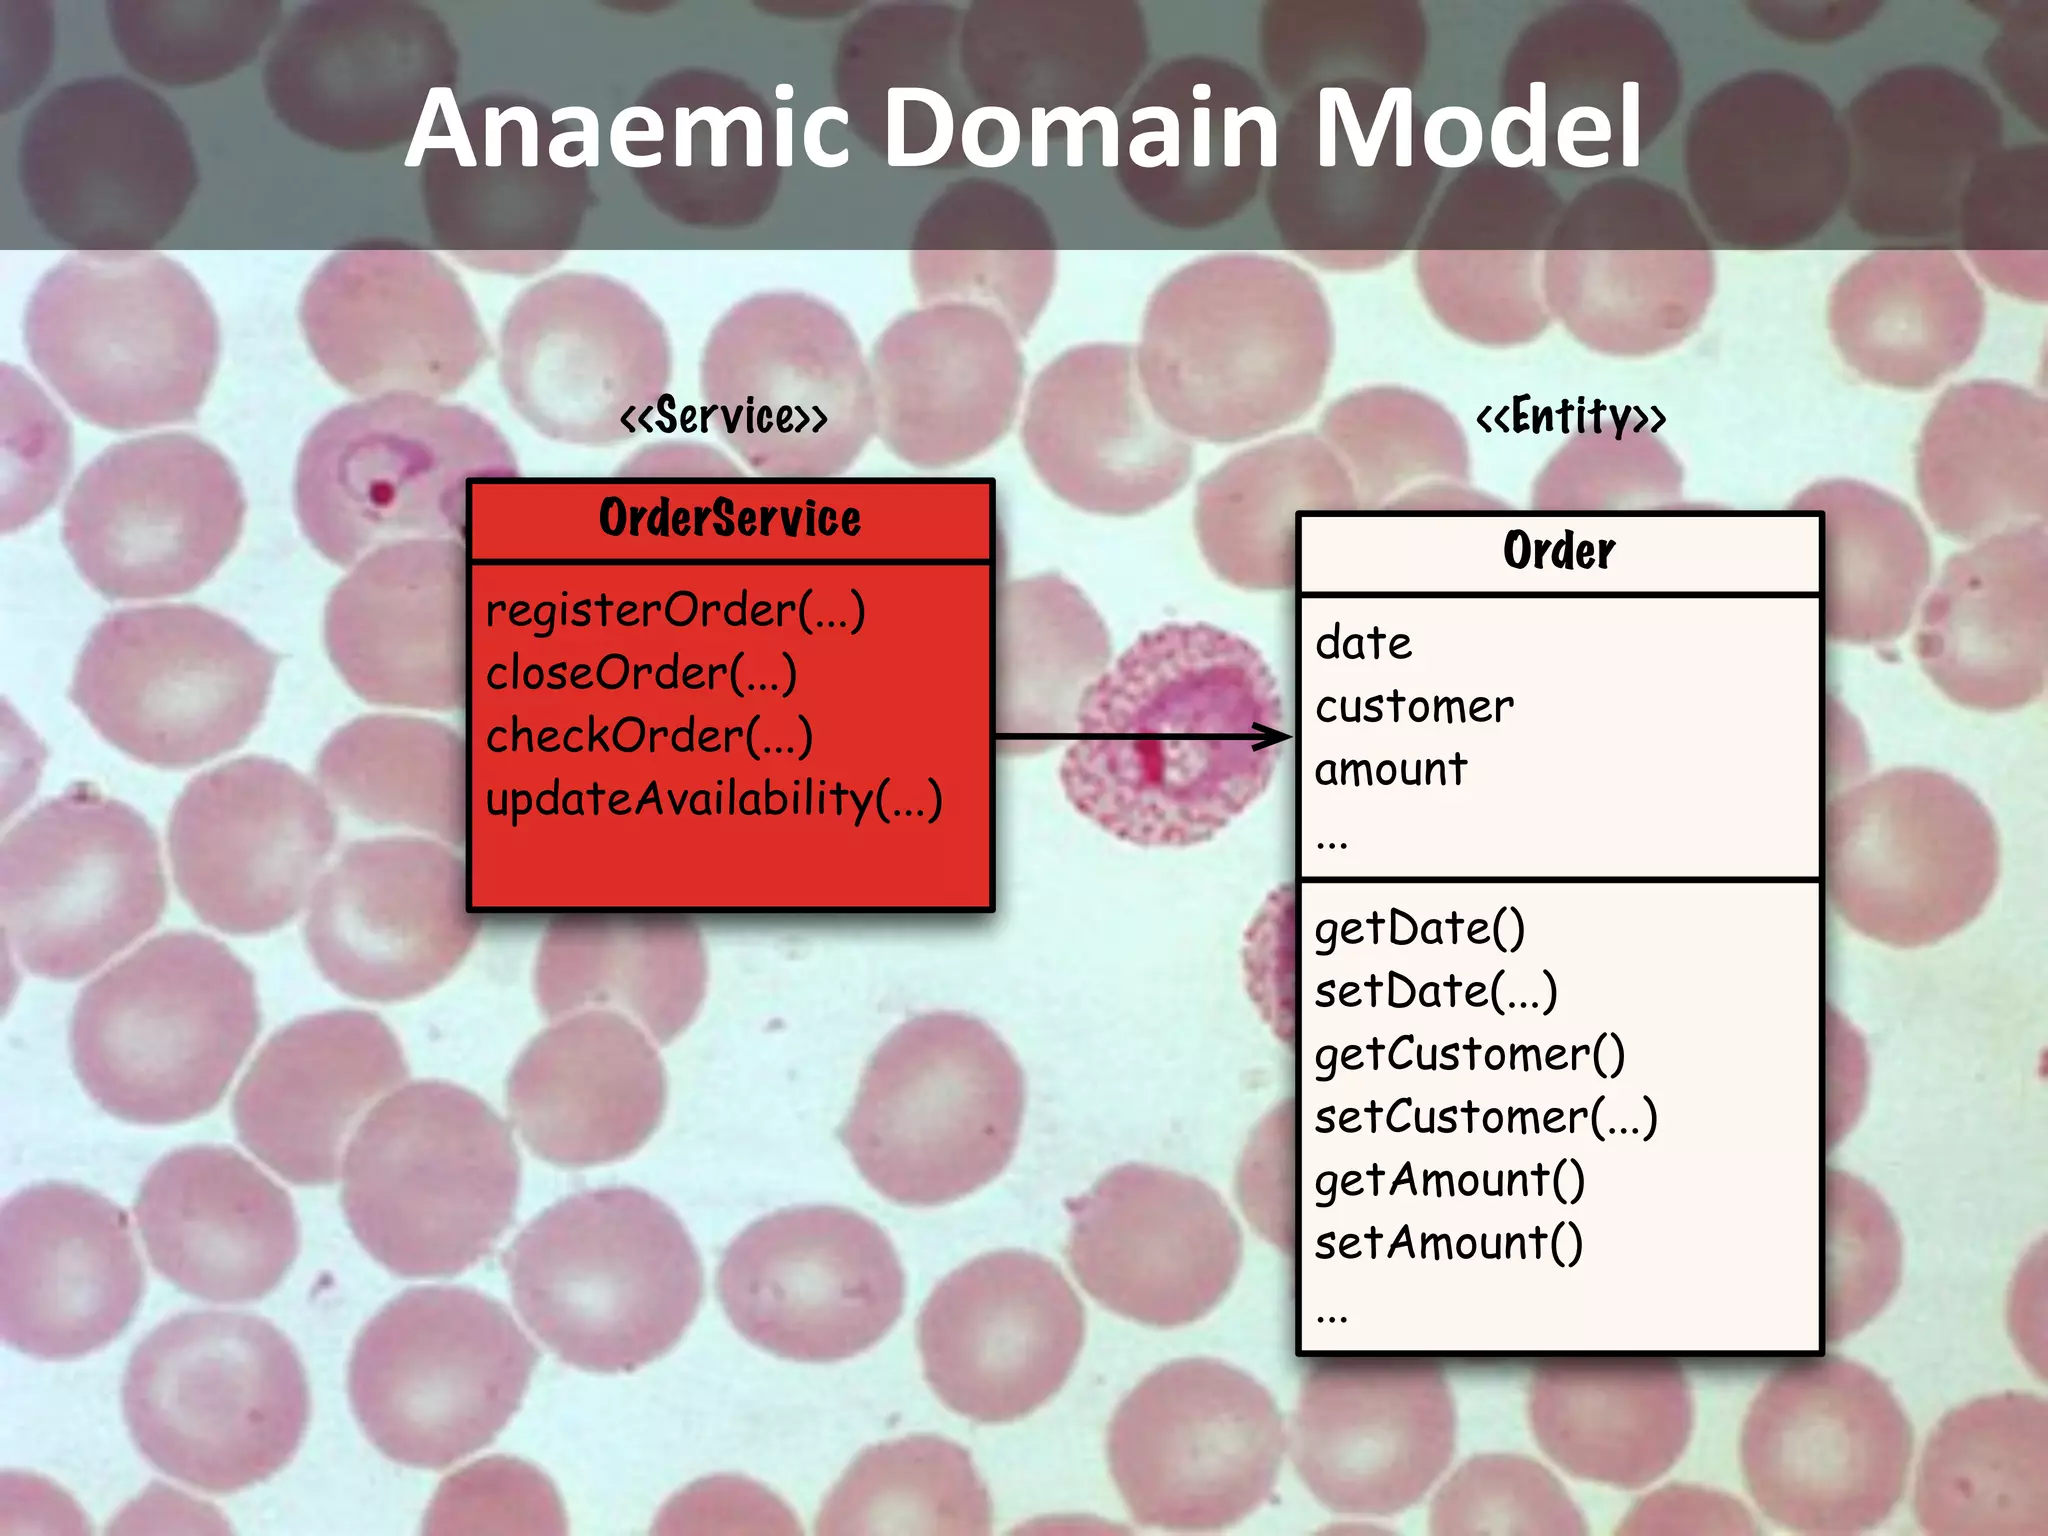
Anaemic Domain Model

       <<Ser vice>>               <<Entity>>

      OrderService
                                   Order
 registerOrder(...)
                           date
 closeOrder(...)
                           customer
 checkOrder(...)
                           amount
 updateAvailability(...)
                           ...

                           getDate()
                           setDate(...)
                           getCustomer()
                           setCustomer(...)
                           getAmount()
                           setAmount()
                           ...
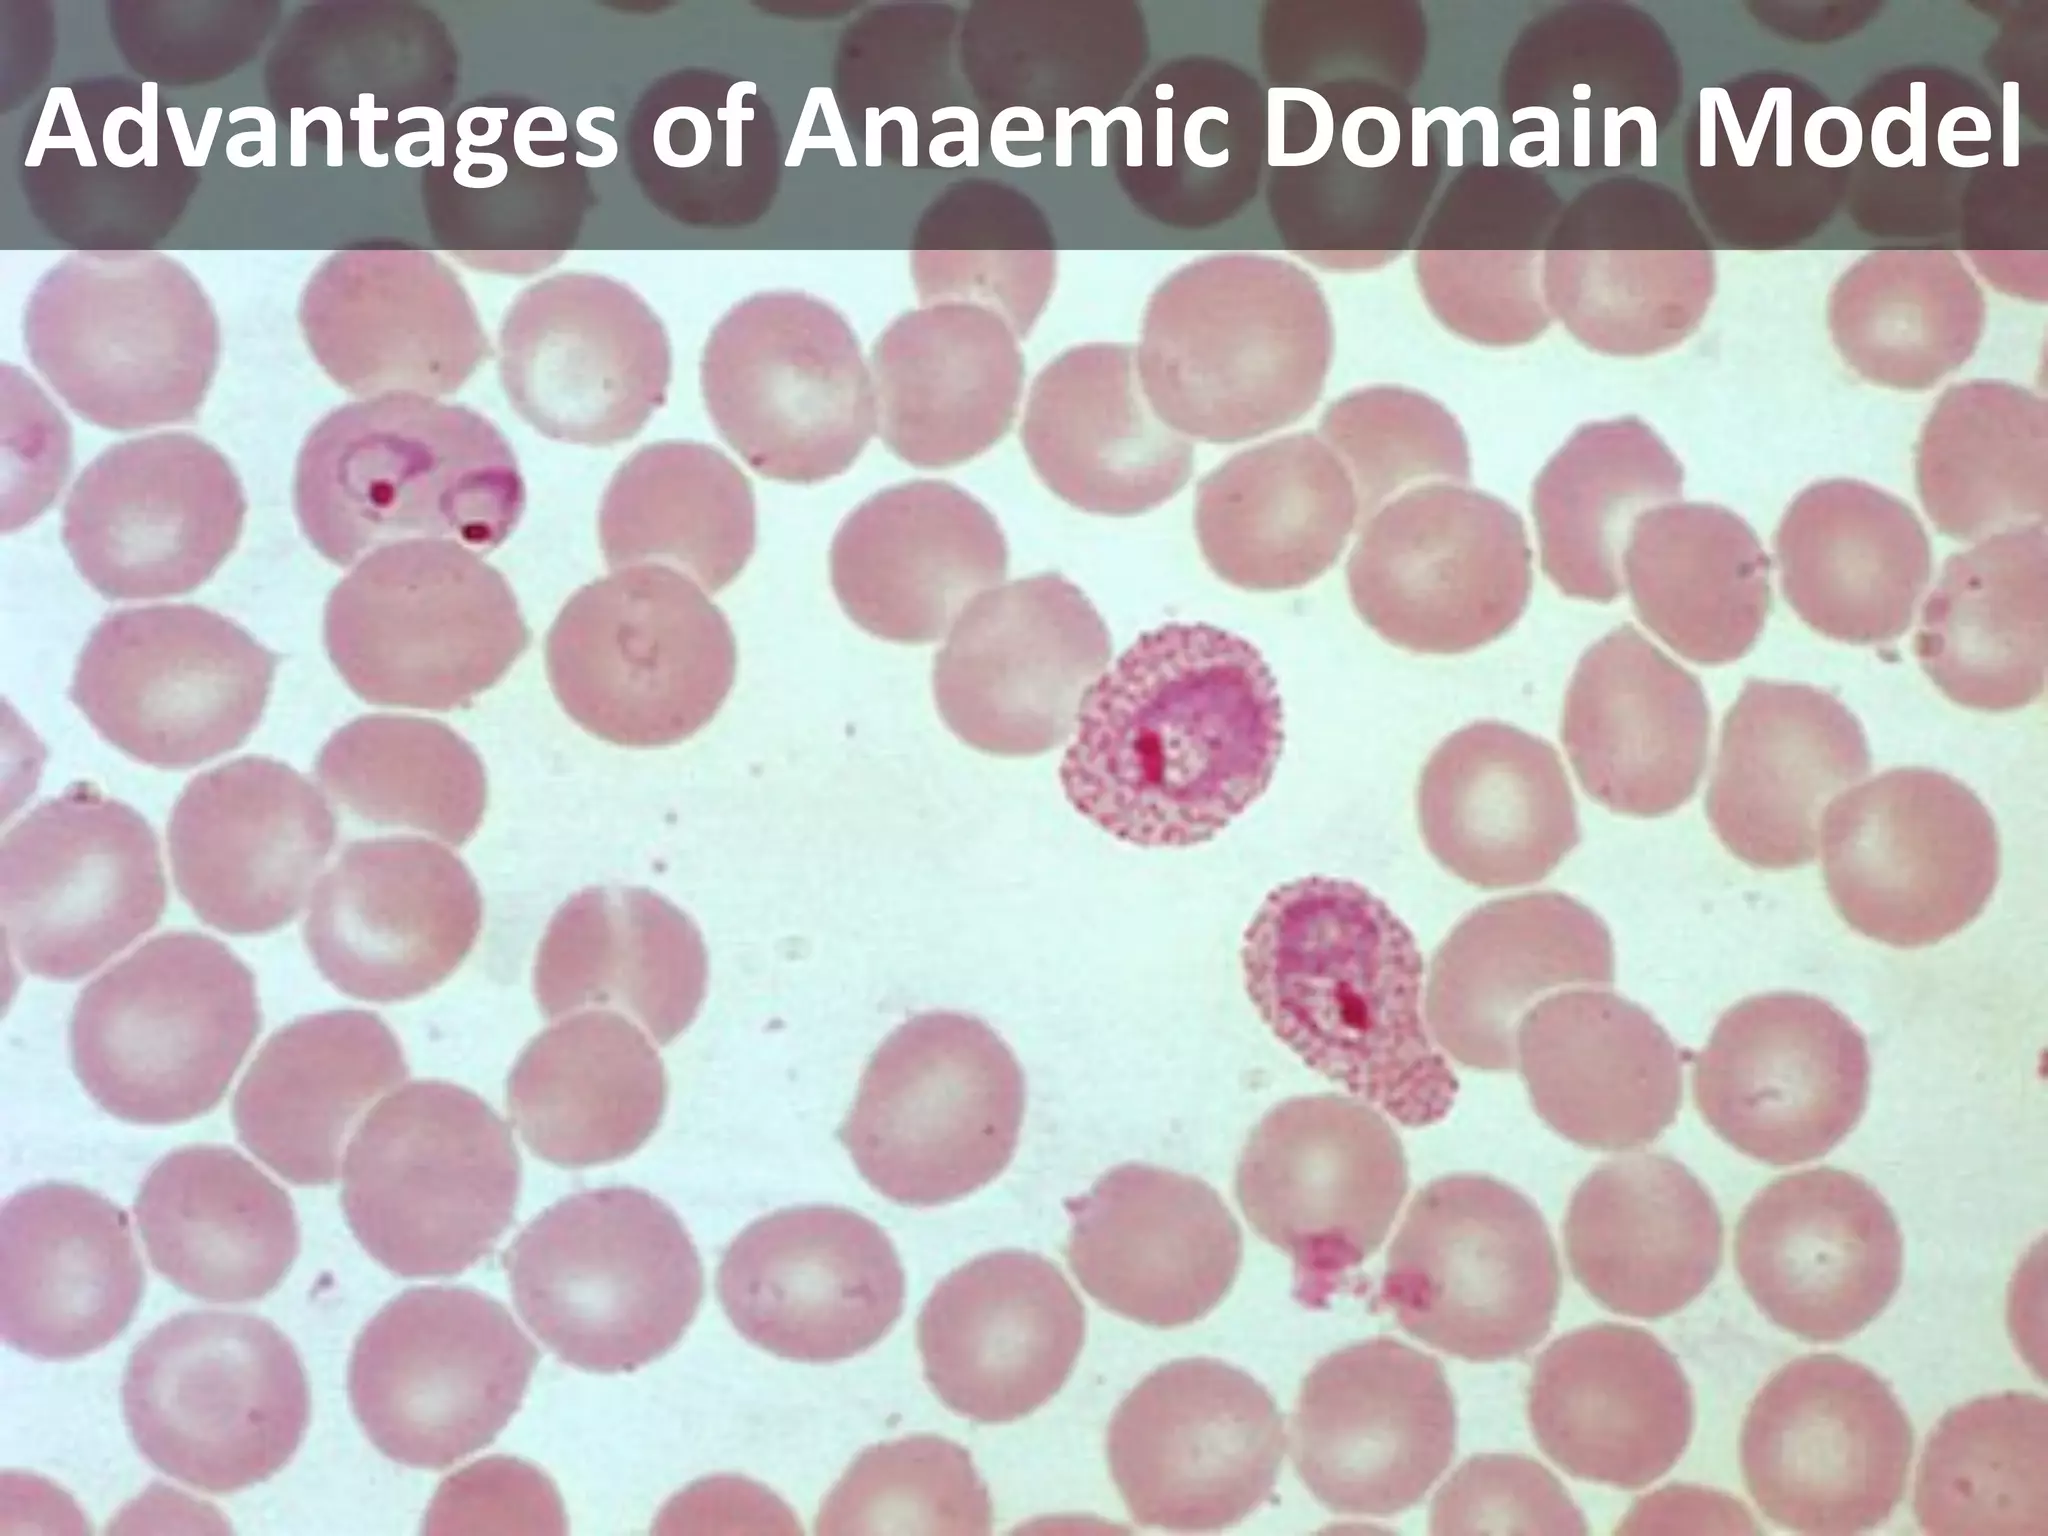
Advantages of Anaemic Domain Model
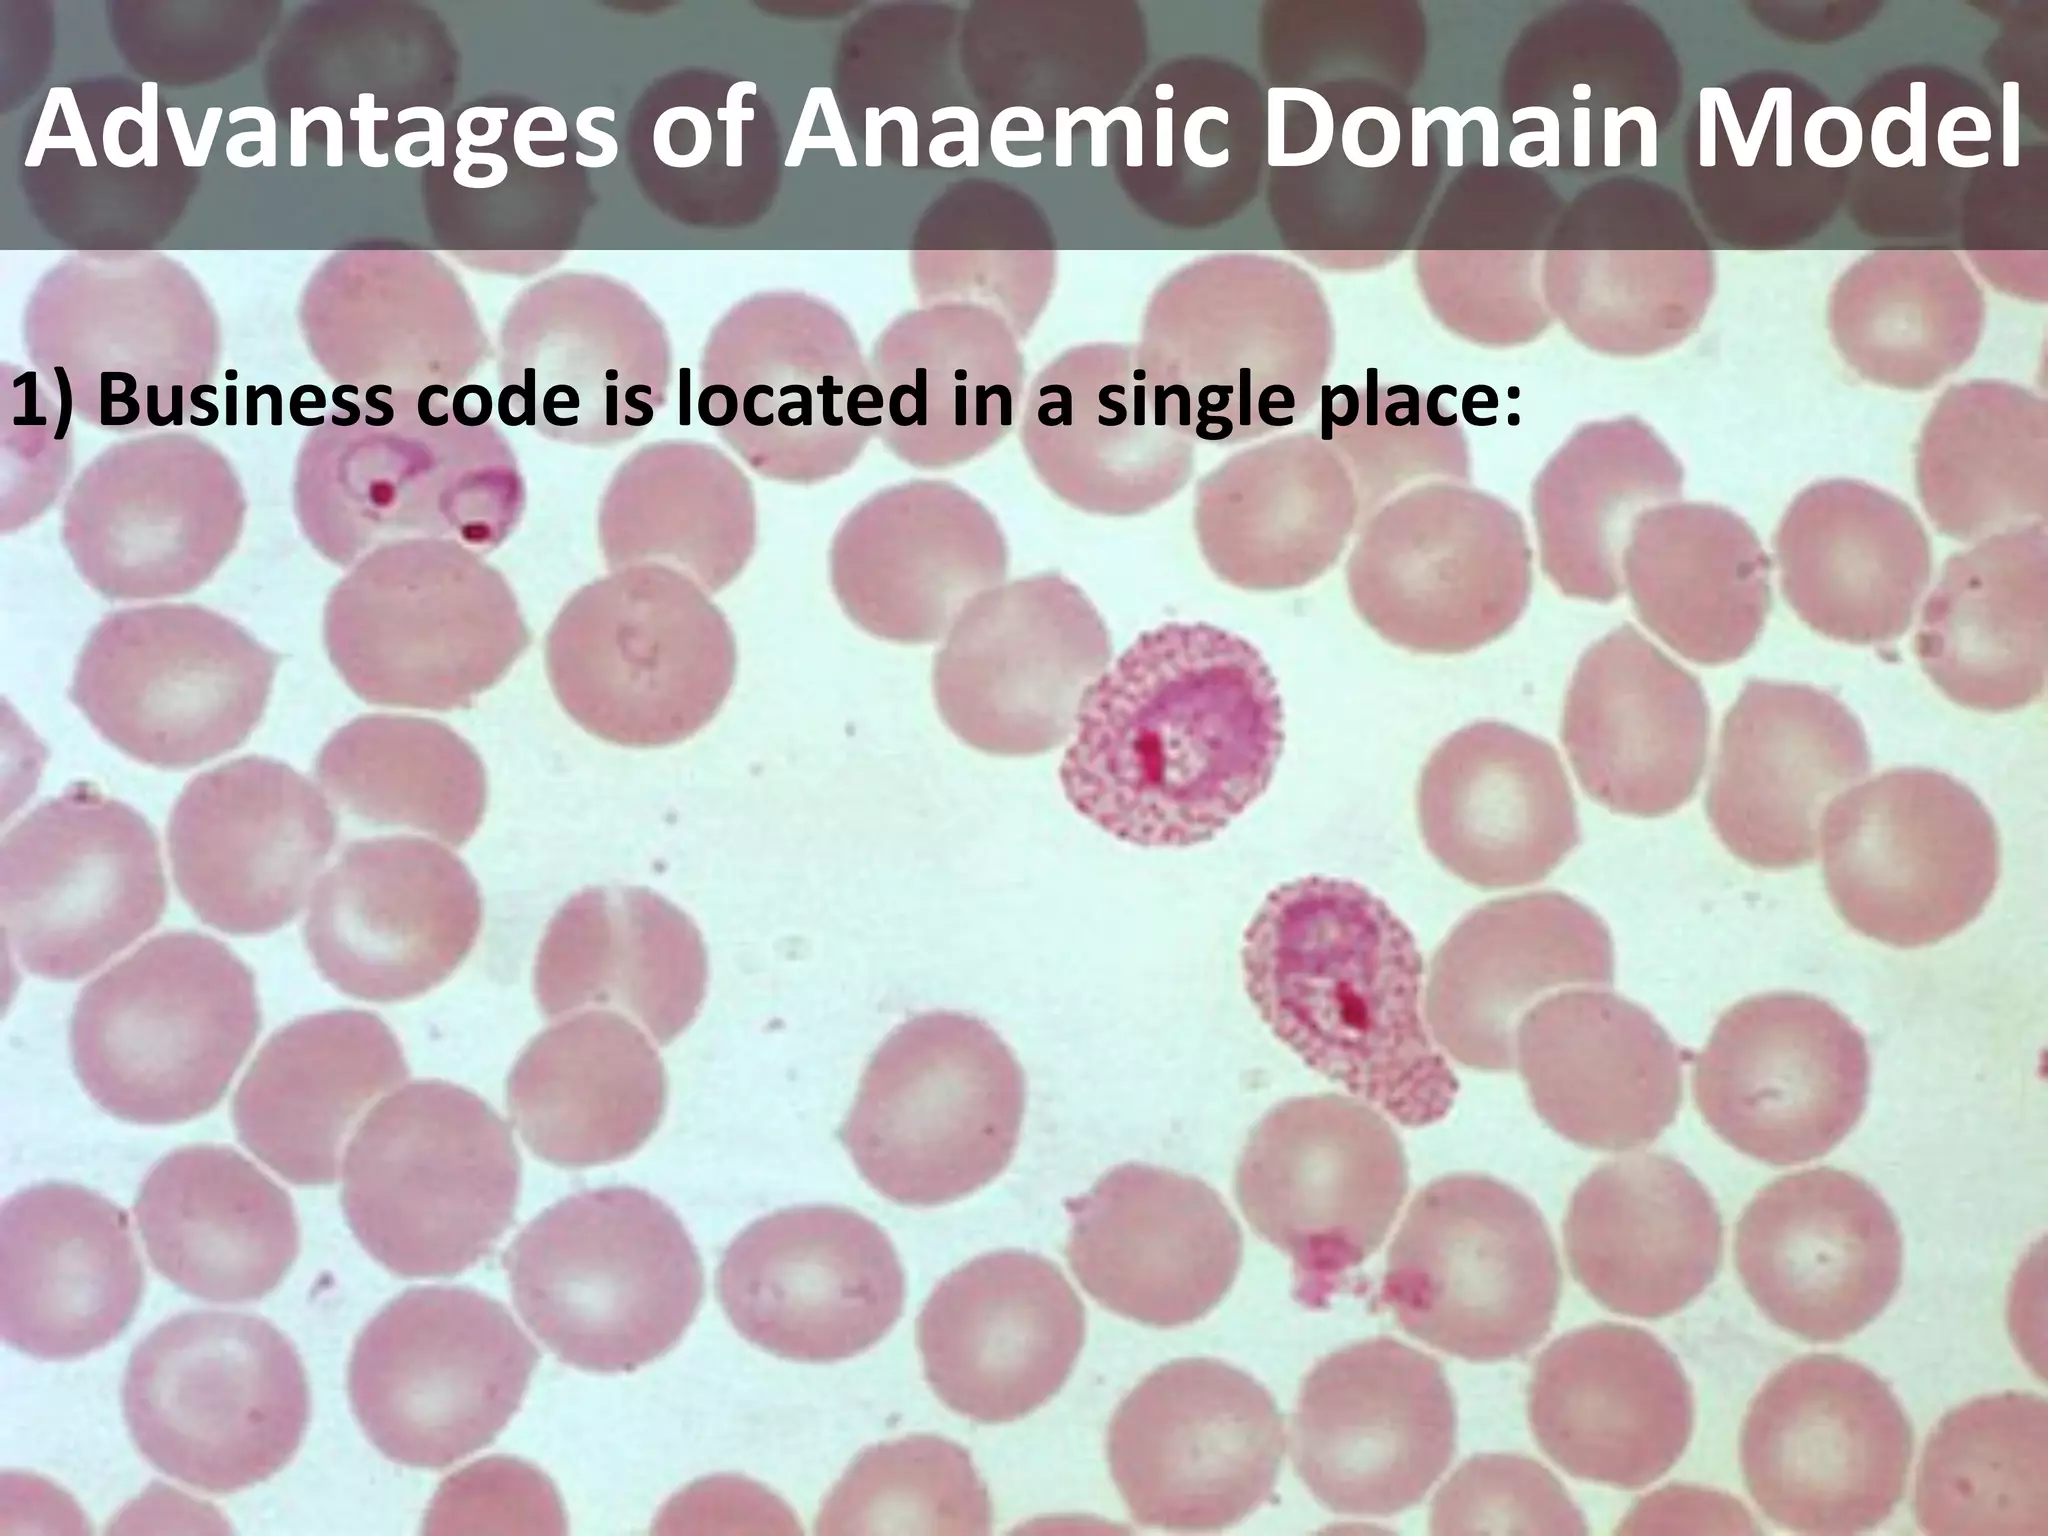
Advantages of Anaemic Domain Model

1) Business code is located in a single place:
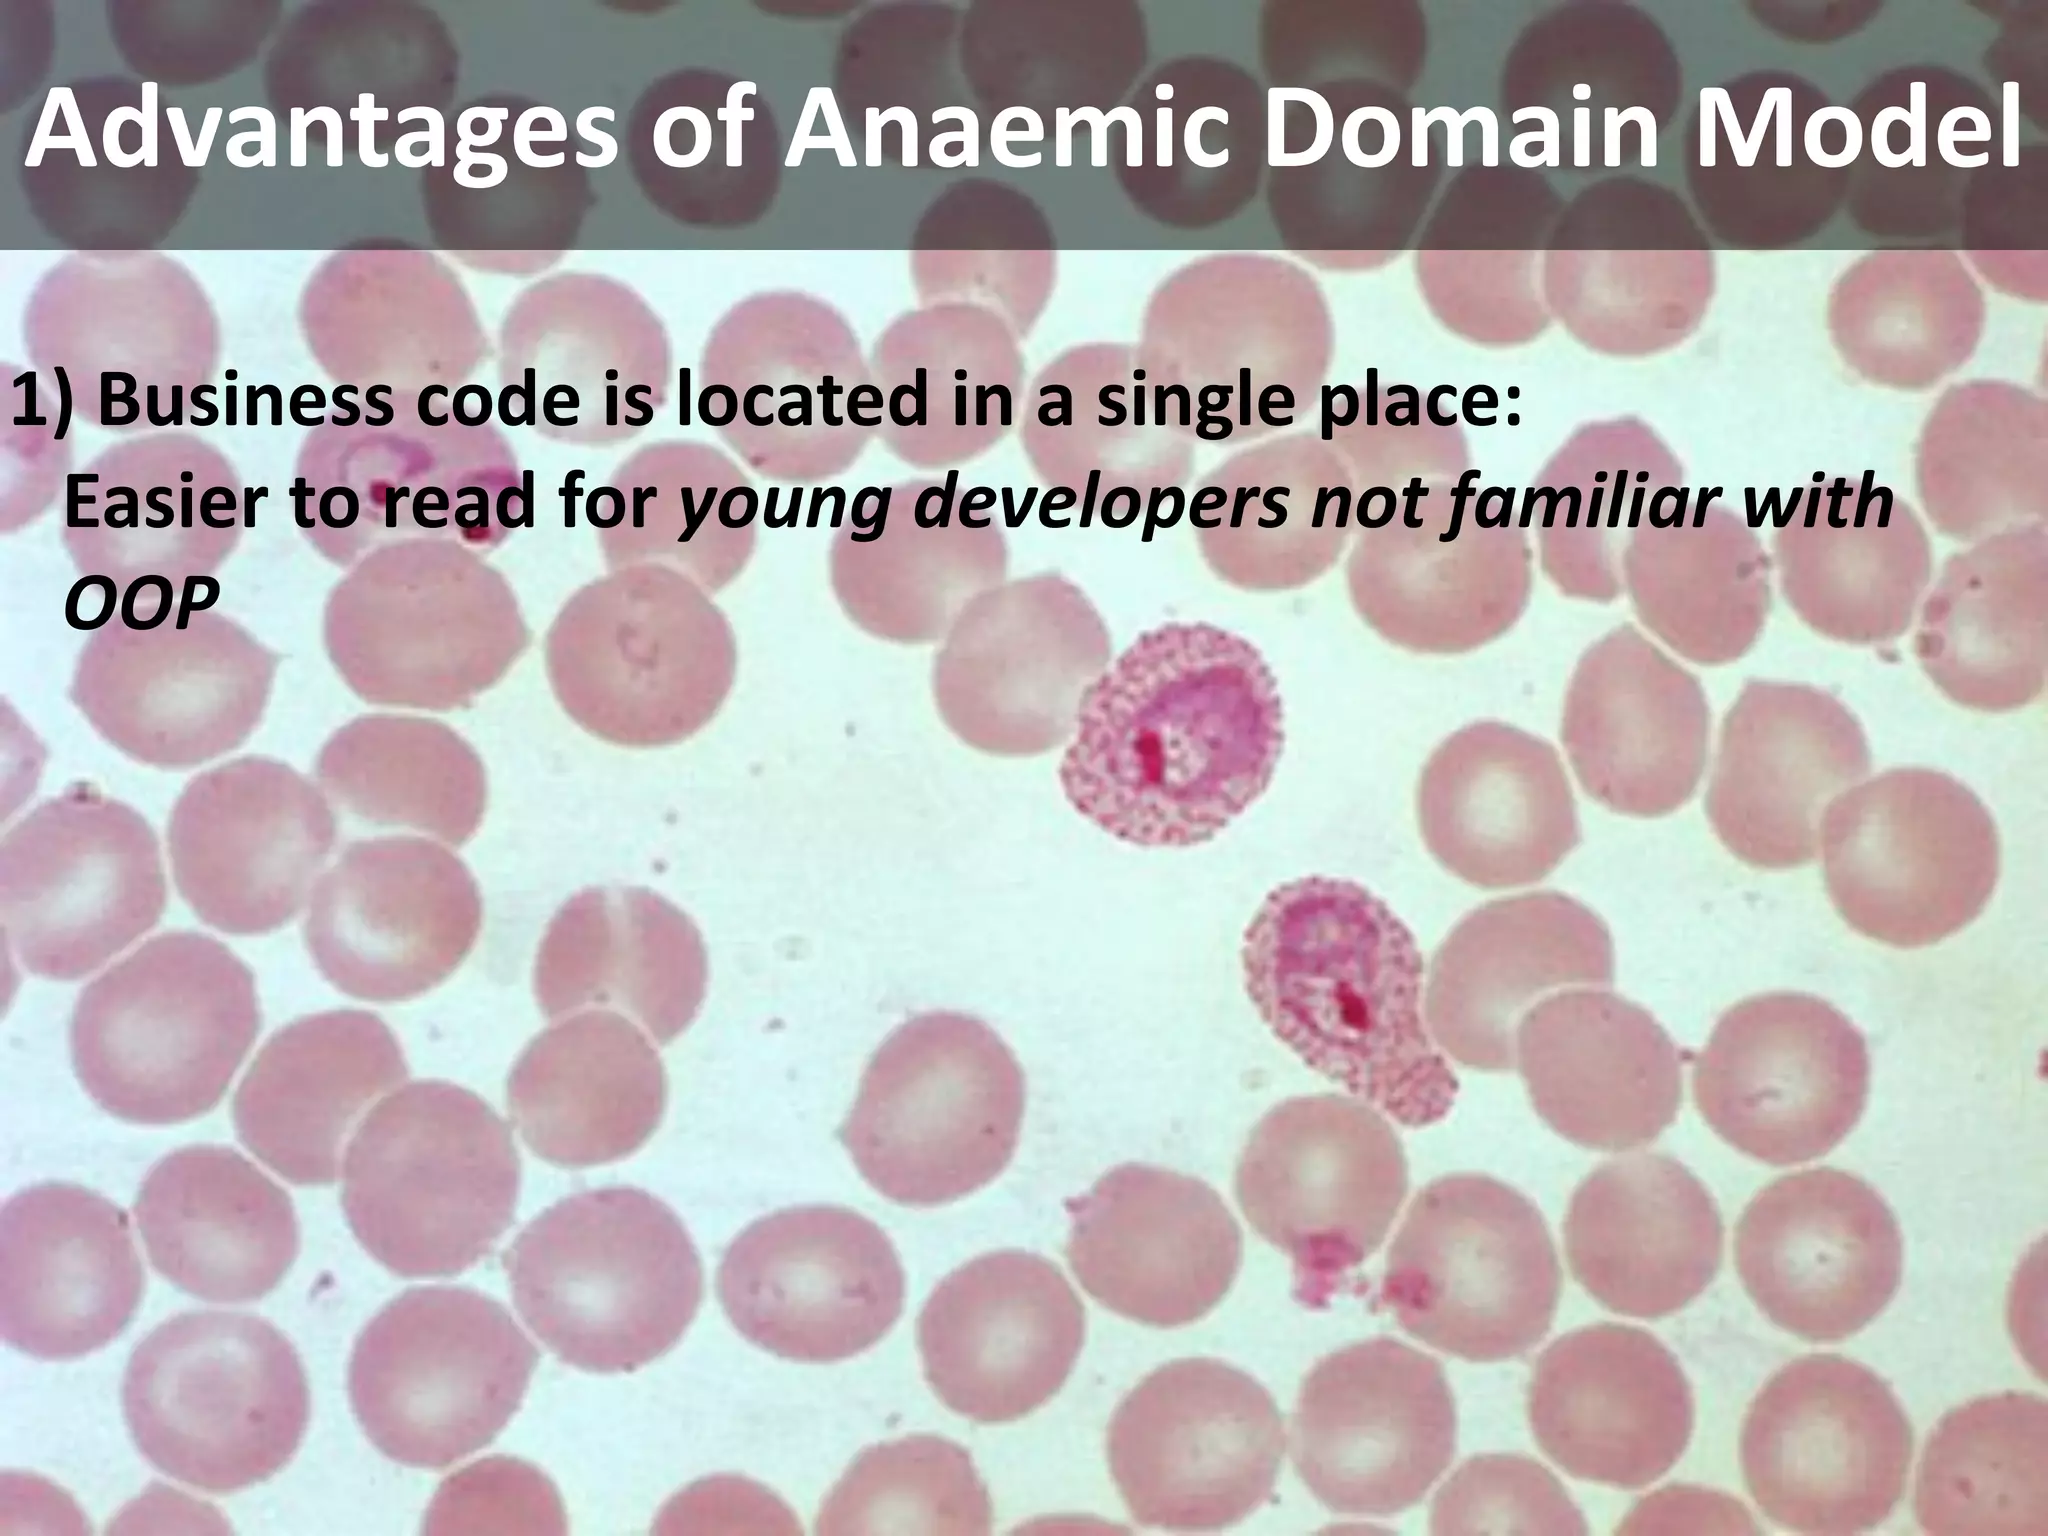
Advantages of Anaemic Domain Model

1) Business code is located in a single place:
 Easier to read for young developers not familiar with 
 OOP
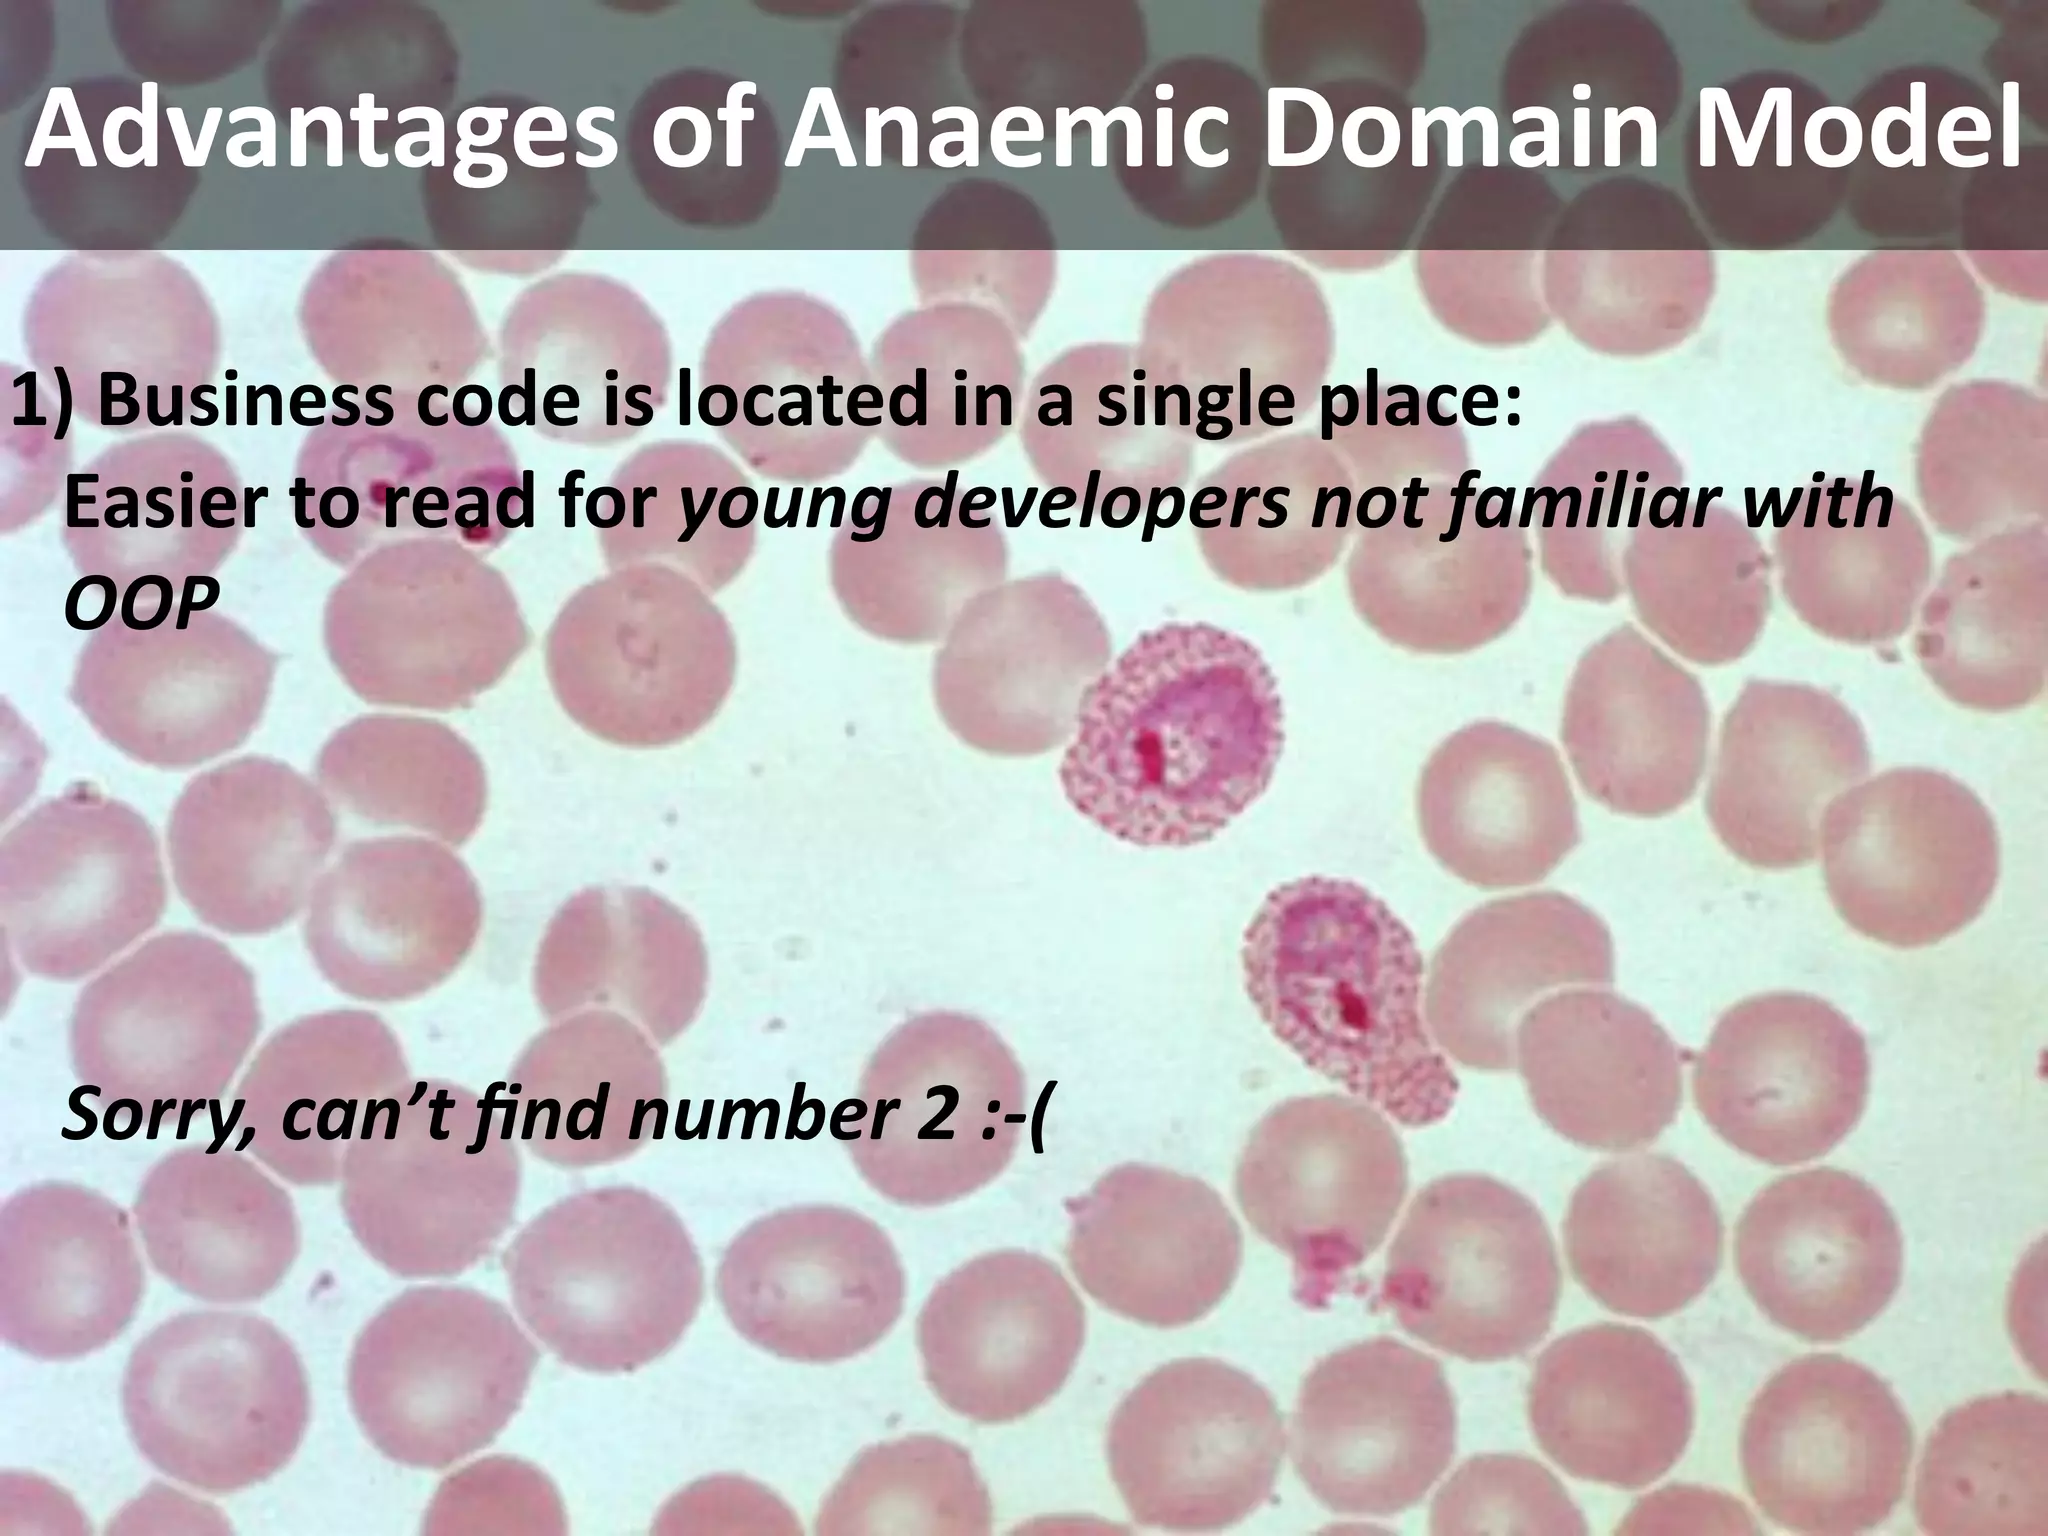
Advantages of Anaemic Domain Model

1) Business code is located in a single place:
 Easier to read for young developers not familiar with 
 OOP




 Sorry, can’t ﬁnd number 2 :‐(

The document discusses the disadvantages of an anemic domain model, where business logic is separated from the domain objects, making the model hard to maintain, test, and prone to duplication. It also suggests that a domain model should contain behavior, use the ubiquitous language, define aggregates as consistency boundaries, and protect the model with bounded contexts.